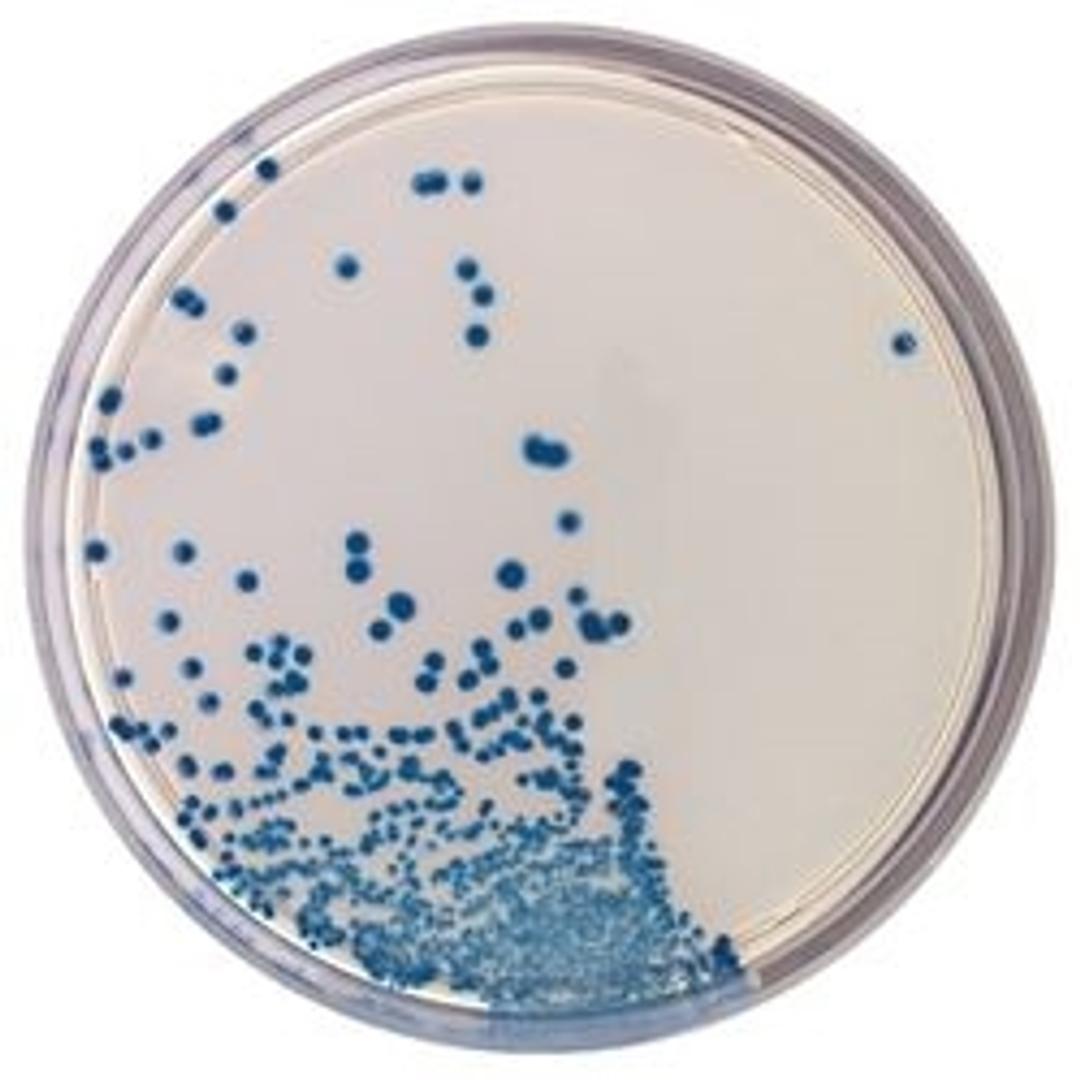
BD BBL™ CHROMagar™ CPE Plate

BD BBL™ CHROMagar™ CPE Plate
For detection of carbapenemase-producing Enterobacteriaceae (CPE)

The supplier does not provide quotations for this product through SelectScience. You can search for similar products in our Product Directory.
The BBL™ CHROMagar™ family of products utilize a chromogen mix that consists of artificial substrates (chromogens) that release differently colored compounds upon degradation by specific microbial enzymes, thus assuring the direct differentiation of certain species or the detection of certain groups of organisms with only a minimum of confirmatory tests.
BD BBL™ CHROMagar™ CPE
• Detects carbapenemase-producing Enterobacteriaceae (CPE) in 18 hours.
• Direct identification of E. coli and detection of the Klebsiella-Enterobacter-Citrobacter-Serratia and Proteus-Morganella providencia groups of organisms
• The media demonstrated a 100% sensitivity (21/21) and 94% specificity (206/227) in an external performance evaluation.
Note: Not all products are available in all geographies, please contact your local BD representative for product details, specs, or ordering information.